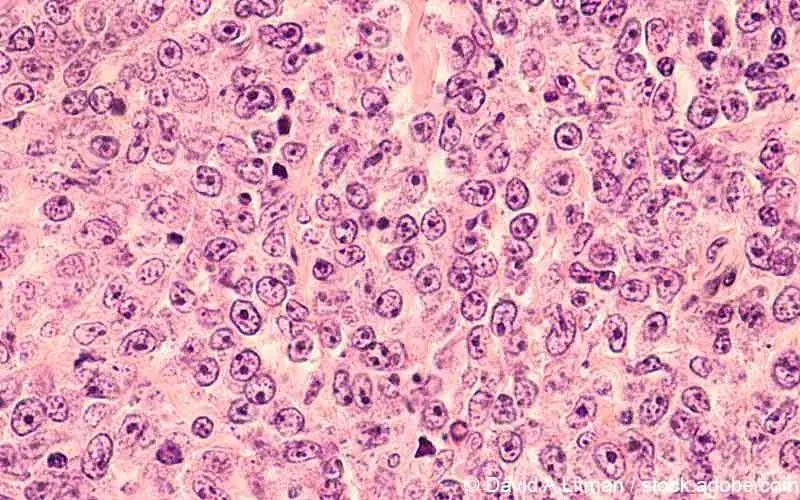
dlbcl

Die American Society of Hematology ist eine medizinische Fachgesellschaft mit Sitz in Washington, D.C. Die American Society of Hematology hat mehr als 18.000 Mitglieder und ist eine der wichtigsten Fachgesellschaften auf diesem Gebiet. Ziel der Jahrestagung, die regelmäßig im Dezember stattfindet, ist der Austausch internationaler Experten in zahlreichen Sitzungen und die Vorstellung von tausenden Abstracts zu aktuellen Forschungsergebnissen und wichtigsten Neuerungen in Therapie und Diagnose. Wir waren für Sie beim 63. ASH dabei und informieren über einige Highlights.